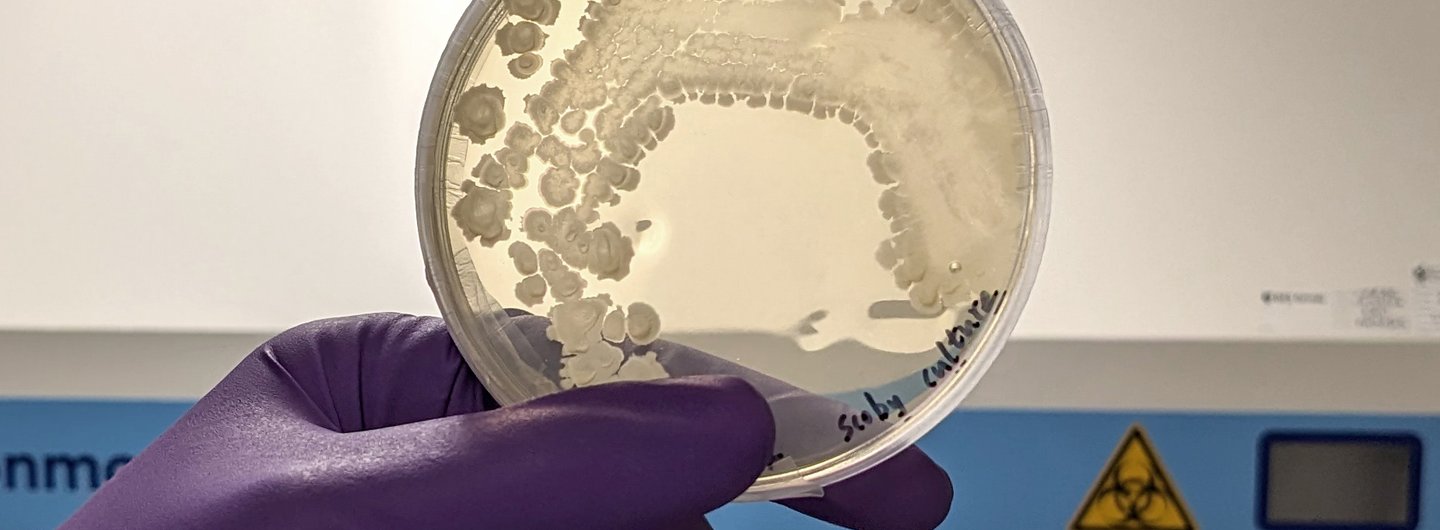

The Bio Lab Residency Programme invites current RCA students or recent graduates into the Bio Lab to work on biomaterials projects.

Biomaterials are of great interest in today’s climate as there is a global need for more sustainable materials and circular, regenerative materials systems – characteristics captured by nature-derived and -inspired materials. In-house research into biomaterials is performed in the Materials Science Research Centre Biomaterials Laboratory, which is a containment level 1 space for inter- and transdisciplinary collaborations between design, materials science, biotechnology, advanced manufacturing and engineering, and environmental science.
During the academic year 2024/25, the Centre ran two Residencies, each taking place over a month, in which two current RCA students or recent graduates came into the Bio Lab to undertake a selection of activities focused on establishing laboratory processes.

Our first Residency took place in November 2024 and was focused around bacterial cellulose and SCOBY, a popular biomaterial, the production of which via fermentation also makes kombucha.
We were joined in the Lab by:
Yiyuan Bai (below left): an MA Textiles graduate, biomaterial designer and researcher specialising in sustainable design and bio-design.
Eve Crompton (below right): an MA Writing student with a background in Integrative Biology from Harvard University.

“Beyond tools, I learned systematic workflows - how to document experiments, analyse data and iterate methodically. This bridge between craft and lab science has reshaped how I approach material development.”
“I learned how scientific methodologies can be adapted to address artistic, environmental, and societal questions. I saw how my work with the Bio Lab was building toward a larger ethos of socially engaged creative practice.”

Our second Residency ran from May to June 2025. We expanded lab work by growing strains of algae as well as establishing processes for making bioplastics (using ingredients such as alginate and carrageenan), which are naturally produced by algae. We also explored further innovative processes and uses for algae-derived materials.
The students who took part were:
Yuki Abe (below left): an RCA/Imperial MA/MSc Innovation Design Engineering student exploring how design addresses societal challenges.
Rosalie Valentiny (below right): an RCA/Imperial MA/MSc Innovation Design Engineering student with a background in biomaterials research.

“A particular highlight was experimenting with microalgae in gel form as a material for 3D printing… It opened my eyes to the potential applications of this technology and material.”
“I really enjoyed my time at the Bio Lab Residency. In particular, working as a trio on biomaterials, as I had mostly worked in that field solo. It was really great to be able to work with people from different backgrounds and cultures, because of the diversity of ideas and approaches that flowed from that. I want to continue to grow as a creative working at the intersection of design, science and well-being.”

All four of this year’s Residency students will take their laboratory skills forward to further develop their practices.
Eve is returning to biomedicine.
Yiyuan is advancing her herbal-based biomaterials practice through entrepreneurship.
Yuki is planning to continue exploring the potential of transforming waste materials into high-value resources through design projects.
Rosalie is looking for a job within the world of biomaterials or systemic design.
“Although I am passionate about material innovation and design, my background is not in science, biology, or material engineering, and the MSRC Bio Lab Residency gave me invaluable hands-on experience, allowing me to expand my practice in ways I couldn’t have elsewhere.”

Our experiences with the Residency programme and welcoming a group of budding researchers and practitioners into the Lab underscores that collaboration is crucial for advancing the power of research.
As the new academic year approaches, the Centre is pleased to announce that our next Residency will take place in November 2025, focusing on mycelium processes. This opportunity is open to current RCA students and recent RCA graduates - please look out for further details in email newsletters or around the RCA campuses.
Written by Dr Kailash Ramlaul.
More information
About the Materials Science Research Centre
The Materials Science Research Centre is one of the RCA’s four Research Centres, situated in the Rausing Research & Innovation Building in the Battersea campus. Research in the Centre focuses on the development of new materials, materials systems and human experiences of materials in addressing global challenges within the contexts of environmental sustainability, human health and wellbeing and the circular economy.
The Centre is led by Professor Sharon Baurley, Professor of Design & Materials, and supported by an interdisciplinary research team comprising Dr Bruna Petreca, Reader in Human Experience and Materials, and Dr Miriam Ribul, Senior Research Fellow in Materials Circularity for Distributed Manufacture. MSRC has developed two laboratories for in-house research: the Immersion Lab and the Biomaterials Lab.
About the Bio Lab
The Lab officially launched in September 2024, and in the past year has opened its doors for a number of opportunities supporting the Centre's research into biomaterials, including cross-College collaborations. The Bio Lab is run by Dr Kailash Ramlaul, Lab Manager & Specialist Technical Instructor in Biomaterials.